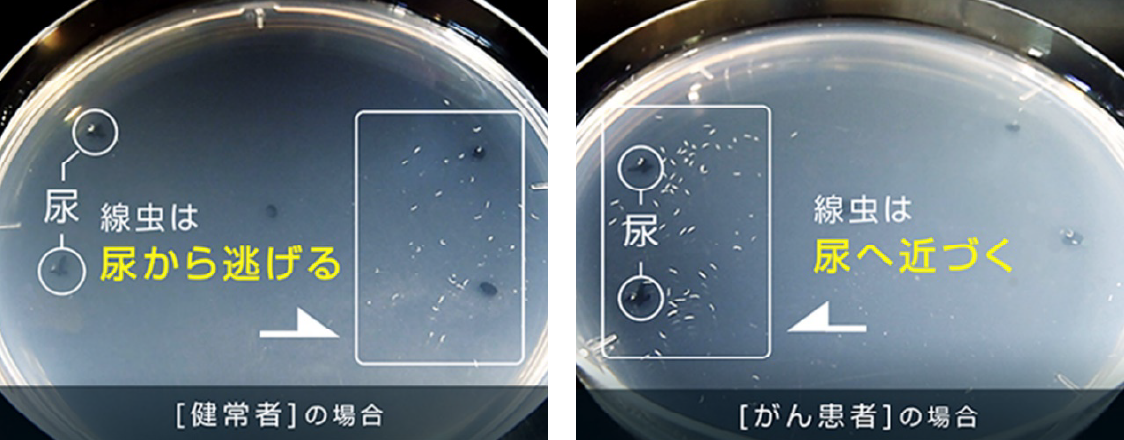

新入荷
再入荷
N-NOSE 線虫がん検査
 タイムセール
タイムセール
終了まで
00
00
00
999円以上お買上げで送料無料(※)
999円以上お買上げで代引き手数料無料
999円以上お買上げで代引き手数料無料
通販と店舗では販売価格や税表示が異なる場合がございます。また店頭ではすでに品切れの場合もございます。予めご了承ください。
商品詳細情報
| 管理番号 |
新品 :4389813122
中古 :4389813122-1 |
メーカー | c6ab9a1b3cad98 | 発売日 | 2025-06-14 15:51 | 定価 | 12500円 | ||
|---|---|---|---|---|---|---|---|---|---|
| カテゴリ | |||||||||

![日野晃の武学 全3巻セット [DVD]](https://static.mercdn.net/item/detail/orig/photos/m97324691156_1.jpg)




